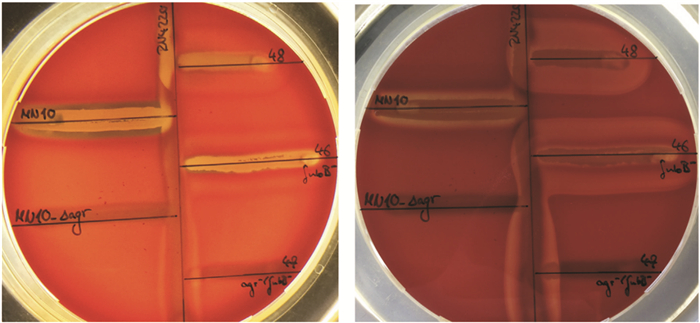

金黄色葡萄球菌(Staphylococcus aureus,SA)是定植在人皮肤表面的革兰阳性菌,是适应能力最强的人类病原体之一,它是一种条件致病菌,可以引起广泛的感染,从轻微的皮肤感染到术后伤口感染、中枢神经系统感染、呼吸道感染、尿路感染甚至败血症等[1-4]。1961年Jevons在英国首次分离到耐甲氧西林金黄色葡萄球菌(methicillin-resistant Staphylococcus aureus,MRSA),至今MRSA逐渐成为一个全球范围内严重的公共卫生问题,可引起严重的软组织脓肿、坏死性肺炎、败血症甚至导致死亡,延长住院日,增加住院费用[5]。本文将对我国儿童金黄色葡萄球菌的流行克隆、溶血表型及其研究进展做一综述。
1 ST59克隆已成为无论是社区获得性还是医院获得性的MRSA感染的主要流行克隆在我国,有关院内获得性耐甲氧西林金黄色葡萄球菌(HA-MRSA)的流行病学信息在1998年之前鲜有报道,参照SENTRY的研究结果,HA-MRSA的分离率在2000年以前维持在较低水平,约占13%~27.8%(资料来源于1998-2001年3家医院的报道)。在2004-2005年的多中心报道中,HA-MESA的分离率增长至50%-62%[8]。2011年来自国内12家医院的统计结果示HA-MRSA的平均分离率为45.8%[9]。
减少和控制MRSA感染的一个重要策略就是明确流行环节,切断传播途径,终止耐药菌株在人群中的播散,选择快捷、可靠的分型方法对于有效控制感染及鉴别菌株十分重要,利用基因技术进行的分子流行病学分型方法成为研究细菌遗传背景和传播的重要手段。最常用的分型方法有:脉冲场凝胶电泳分型(pulsed-field gel electrophoresis,PFGE),多位点序列分型(multilocus sequence typing,MLST),蛋白A重复序列分型(spa分型)和葡萄球菌染色体SCCmec(staphylococcal cassette chromosome mec,CCmec)基因盒分型等。从多位点序列分型(MLST)结果来看,世界不同地区HA-MRSA的流行克隆是不同的,在欧洲HA-MRSA的流行克隆常见为CC30克隆,例如在英国是ST22和ST239克隆[10];在北美,日本和韩国是ST5克隆[11-13],在大部分亚洲国家和澳大利亚是以ST239为主要流行克隆,而我国台湾、香港地区则以ST239、ST5两个克隆为主要流行克隆[14-15]。ST239-SCCmecⅢ是澳大利亚、亚洲和南美洲院内获得性MRSA的主要流行克隆,流行病学研究使用全基因组测序的方法发现此克隆衍生于局部地区,偶然的时机使其传播到其他大洲[16]。20世纪90年代以来,ST239-SCCmecⅢ/ⅢA为我国院内获得性MRSA的主要流行克隆,2005-2006全国范围内14个城市的18家医院的HA-MRSA中,77.1%为ST239-SCCmecⅢ,15.5%为ST5-SCCmecⅡ[17]。本课题组的前期研究表明2010年之前我国儿童HA-MRSA的主要流行克隆也为ST239克隆,ST239克隆可引起多种侵袭性感染,如重症肺炎,骨关节炎,败血症等,大多数ST239克隆菌株对四环素,红霉素,克林霉素,庆大霉素,妥布霉素和环丙沙星耐药[18-19]。
世界不同地区社区获得性CA-MRSA主要流行克隆也是不同的,美国2001年之前主要的流行克隆为USA400[20]即ST1型[21-22],从2000年至今,在美国不同地区不同的人群中CA-MRSA曾有多次爆发[23-24],USA300即ST8已经取代了ST1成为了社区感染MRSA的主要流行克隆[25-26]。在欧洲地区流行的则为ST80、ST1及ST30,非洲地区为ST30,澳大利亚地区为ST93,在台湾和香港地区主要流行克隆为ST59,中国大陆地区成人中主要流行ST239克隆[27],儿童则主要为ST59克隆[28-29]。但2016年的研究结果表明,ST239克隆已经在北京儿童医院范围内消失,取而代之的是社区获得性ST59克隆,成为无论是社区还是医院获得性MRSA感染的主要流行克隆。ST59克隆侵袭力增强[30],表现在免疫逃逸能力增强[31-32]、细菌适应能力强、生长繁殖及传播迅速,目前造成MRSA ST59克隆侵袭力增强的确切机制尚不清楚。
2 我国儿童ST59克隆δ溶血素功能缺陷,保留了α溶血功能所有的金黄色葡萄球菌(包括MRSA和MSSA)主要是向宿主的细胞表面或细胞外环境排出一系列的致病因子而致病。这些因子包括:(1) 介导MRSA定植和入侵的黏附因子如:蛋白A (Spa)[33]、中毒休克综合征毒素-1 (TSST-1)、葡萄球菌肠毒素B (SEB)、杀白细胞素(PVL)、精氨酸分解代谢可动元件(ACME)、纤维蛋白结合蛋白等。(2) 细胞溶解素:α-溶血素(α-毒素;基因hlα)、β-溶血素(β-毒素;基因hlβ)、γ-溶血素(γ-毒素;基因hlgA、hlgB、hlgC)、δ-溶血素(δ-毒素;基因hlδ)[34]。(3) 杀白细胞素:PVL、γ-溶血素(HlgB和HlgC)等。(4) 细胞溶解肽:δ-溶血素基因、PSMα基因(4个连接的重复基因,PSMα1~PSMα4) 和PSMβ(2个连接的重复基因,PSMβ1和PSMβ2)[35-36]。(5) 超抗原:TSST-1(即之前的SEF)等。(6) 剥脱毒素(Exfoliative toxin):包括ETA、ETB和ETD。
2016年研究者发现动物来源的agr缺陷菌株(CC398/t2741) 表现为α、δ溶血素功能均缺陷,说明动物来源的菌株agr调控系统可调节α溶血素、PSMα和δ溶血素,而且在agr基因敲除以后表现为α、δ溶血功能均消失(图 1)[37]。但是临床来源的菌株则表现出与动物来源菌株表现不同,图 2为美国MRSA流行克隆USA300菌株,可见在agr基因敲除之后,α溶血素的RNA表达量有所下降,但不是零[38]。来源于我国上海的MRSA ST59克隆的实验结果(图 3)也表明,在agr基因敲除后,PSMα的RNA表达量降至零,而α溶血素的RNA表达量有所下降,但同样不是零[39]。研究结果(图 5)表明,ST59克隆RNAⅢ、α溶血素、PSMα的RNA表达量高于其他克隆,说明在转录水平,RNAⅢ、α溶血素、PSMα的表达量没有降低[40],但是ST59克隆却普遍表现出δ溶血功能障碍,所以我们推测在毒力因子的翻译水平的某种调控机制使其蛋白生成障碍,进而导致功能缺陷。美国金黄色葡萄球菌USA300克隆(图 4)表现出了很强的α溶血作用,而δ溶血作用缺陷,说明其Agr功能缺陷[41]。本课题组近期的研究结果表明,与其他克隆相比,儿童的金黄色葡萄球菌流行克隆ST59临床分离株表现为δ溶血素功能缺陷,但是保留了α溶血功能,表明来源于人的菌株与来源于动物的菌株关于α溶血素的调控机制是不同的,动物来源的菌株α溶血素、PSMα、δ溶血素均受Agr调控系统调节,agr基因敲除后,上述三种溶血作用消失。而对于来源于人的菌株而言,Agr调控系统调节PSMα、δ溶血素的产生,但是α溶血素的调控则表现为受多种调控系统调节,而不仅仅接受Agr调控系统的调节。由上可见,Agr调控系统及其调控的溶血素因子,对于动物来源菌株而言,agr调控系统可严格调控α溶血素、PSMα、δ溶血素的产生,但对于来源于人的菌株而言,Agr调控系统对于α溶血素和PSMα、δ溶血素的调控作用出现分化,表现为Agr系统不能同时调控三种毒力因子产生,对于α溶血素的调控出现了变异,临床流行菌株USA300和ST59两种克隆均表现出Agr调控的PSMα、δ溶血素溶血功能缺陷,保留了α溶血素的溶血作用,那么,这种溶血功能发生变异的机制是什么呢?ST59克隆的溶血素在翻译水平发生了什么机制使其蛋白质功能出现了分化?
|
| 图 1 溶血表型。Agr阴性菌株未表现出溶血(Fin47_H17 and MN_Δagr)。MN10表现出α、δ溶血,Fin46_H17表现出α、β溶血,Fin48_H18表现出δ、β溶血 |
|
|

|
| 图 2 美国LAC(USA300)、LAC Δagr、RN6390、RN6390Δagr、RN6911、RN6911Δagr菌株在agr基因敲除前后α溶血素的RNA表达情况 |
|
|

|
| 图 3 CA-MRSA59克隆agr基因敲除后qRT-PCR测量hlα和PSMα表达量 |
|
|

|
| 图 4 我国儿童各克隆毒力因子表达对比(RT-PCR) |
|
|
众所周知,α溶血素[42]、PSMα[43]、δ溶血素是受Agr(accessory gene regulator)调控系统调节的毒力因子(图 5)[44],Agr系统中心包含两个方向相反的启动子(P2和P3),P2启动子调节RNAⅡ信号途径,通过Agr相关蛋白(A、B、C、D)的表达发挥基因调控功能,psmα基因的表达受AgrA调控;P3启动子调节RNAⅢ(编码δ-溶血素)的表达,葡萄球菌不断向体外分泌自诱导肽(AIPs),当AIPs浓度达到一定临界值时,AIPs与AgrC结合,随之AgrC自动磷酸化激活AgrA,活化的AgrA可结合到启动子基因间的区域,使P2和P3分别启动一个正向的反馈循环和RNAⅢ的转录,P3启动子调节RNAⅢ信号途径,而δ-溶血素基因位于RNAⅢ基因内部,故δ-溶血素的表达与RNAⅢ的表达一致;而RNAⅡ编码的AgrA则直接与PSMα基因的调控子结合,促进PSMα的产生,故δ-溶血素、PSMα是受Agr调控系统严内调控的因子,二者同属于α螺旋肽,可作为Agr调控系统是否有功能的标志[45]。α溶血素的表达则同时受几个调控系统的调控,包括Agr系统、SaeRS系统、ArlRS系统,翻译调节因子Mgr和SarZ;同时,葡萄球菌调节相关因子SaraA,包括Rot和SarT,则抑制α溶血素的产生[44]。此外,还有一种β溶血素,金黄色葡萄球菌工具菌株RN4220表达β溶血素,研究表明动物源性金黄色葡萄球菌大多表达β溶血素,但人源性菌株表达α溶血素,不表达β溶血素,其机制是噬菌体phi 13定向整合染色体编码的β溶血素决定因子的插入灭活作用[46]。Agr调控系统作用具有时效性,在菌株对数生长期的中期,Agr系统激活,启动AIP正循环,同时RNAⅢ会编码δ溶血素,下调细菌表面蛋白基因,如spa蛋白。进入对数生长期的后期的时候,Agr会上调目的基因,如α溶血素。这种时效性不同的菌株会表现不同,如AgrⅣ型菌株存在调控的时效性,AgrⅢ型菌株则表现为非时效性[47]。研究表明,金黄色葡萄球菌工具菌株RN4220菌株表现为Agr功能缺陷,其机制为agrA基因3’端插入一个核苷酸A,使agrA-7A基因变成agrA-8A,agrA-8A突变株可导致蛋白质翻译时氨基酸读码框出现移位,氨基酸由K、K、I变成N、I、I、R,导致RNAⅢ延迟生成,进而使在菌株对数生长期中期翻译生成的α、δ溶血素不能翻译,从而导致其溶血功能缺陷(图 6)[48]。Agr调控系统对α溶血素的调控是通过RNAⅢ实现的,RNAⅢ既可以在菌株对数生长期的中期促进α溶血素的翻译,又可以在菌株对数生长期后期通过Rot实现对α溶血素的上调,研究表明,在Agr功能缺陷菌株[49],如果同时敲除rot基因,则α溶血素的表达显著增强,说明Rot是α溶血素的抑制因子[50-51]。所以,我们推测,我国儿童的临床分离株ST59克隆δ溶血功能缺陷、α溶血功能保留的机制为agrA基因发生了8A突变,使RNAⅢ延迟生成,导致δ溶血素不能翻译,δ溶血功能缺陷,在菌株对数生长期后期,RNAⅢ生成,与Rot结合,抑制其功能,从而钝化Rot功能,解除其对α溶血素翻译的抑制作用,使α溶血素生成,实现α溶血功能。所以推测,ST59克隆临床分离株发生了agrA基因-8A突变,使其在临床环境中适应能力增强,逐渐由社区进入医院,成为无论是社区还是院内获得性MRSA的主要流行克隆。

|
| 图 5 金黄色葡萄球菌Agr调控系统作用机制图 |
|
|

|
| 图 6 Northern blot法检测金黄色葡萄球菌RN4220与其衍生菌RN450-8A变异株不同时间RNAⅢ、α溶血素等RNA的产生情况,8A变异株RNAⅢ表达延迟 |
|
|
总之,金黄色葡萄球菌可导致严重的感染,世界卫生组织已经建议加强对其进行研究,给临床诊断和治疗提供理论依据,减少病死率。中国儿童金黄色葡萄球菌MRSA ST59克隆已经呈现出蔓延的趋势,其独特的溶血表型可能是该克隆蔓延的原因之一,所以加强对该克隆的监测,完善其分子生物学特征,尤其是溶血素表达情况、溶血功能分化的机制研究,可帮助人们更好的了解MRSA ST59克隆。
| [1] | Khokhlova OE, Hung WC, Wan TW, et al. Healthcare-and community-associated methicillin-resistant staphylococcus aureus (MRSA) and fatal pneumonia with pediatric deaths in Krasnoyarsk, Siberian Russia: unique MRSA's multiple virulence factors, genome, and stepwise evolution[J]. PLoS One, 2015, 10(6): e128017. DOI:10.1371/journal.pone.0128017 |
| [2] | 黄娇甜, 祝益民. 儿童金黄色葡萄球菌肠毒素食物中毒196例的临床特征[J]. 中华急诊医学杂志, 2013, 22(5): 468-471. DOI:10.3760/cma.j.issn.1671-0282.2013.05.005 |
| [3] | Galyfos G, Giannakakis S, Kerasidis S, et al. Infective endocarditis as a rare cause for acute limb ischemia[J]. World J Emerg Med, 2016, 7(3): 231-233. DOI:10.5847/wjem.j.1920-8642.2016.03.012 |
| [4] | Foster SD, Lyons MS, Runyan CM, et al. A mimic of soft tissue infection: intra-arterial injection drug use producing hand swelling and digital ischemia[J]. World J Emerg Med, 2015, 6(3): 233-236. DOI:10.5847/wjem.j.issn.1920-8642.2015.03.014 |
| [5] | Thurlow LR, Joshi GS, Richardson AR. Virulence strategies of the dominant USA300 lineage of community-associated methicillin-resistant Staphylococcus aureus (CA-MRSA)[J]. FEMS Immunol Med Microbiol, 2012, 65(1): 5-22. DOI:10.1111/j.1574-695X.2012.00937.x |
| [6] | Bell JM, Turnidge JD. High prevalence of oxacillin-resistant Staphylococcus aureus isolates from hospitalized patients in Asia-Pacific and South Africa: results from SENTRY antimicrobial surveillance program, 1998-1999[J]. Antimicrob Agents Chemother, 2002, 46(3): 879-881. DOI:10.1128/AAC.46.3.880-882.2002 |
| [7] | Christiansen KJ, Bell JM, Turnidge JD, et al. Antimicrobial activities of garenoxacin (BMS 284756) against Asia-Pacific region clinical isolates from the SENTRY program, 1999 to 2001[J]. Antimicrob Agents Chemother, 2004, 48(6): 2049-2055. DOI:10.1128/AAC.48.6.2049-2055.2004 |
| [8] | Xiao YH, Wang J, Li Y. Bacterial resistance surveillance in China: a report from Mohnarin 2004-2005[J]. Eur J Clin Microbiol Infect Dis, 2008, 27(8): 697-708. DOI:10.1007/s10096-008-0494-6 |
| [9] | Wang H, Liu Y, Sun H, et al. In vitro activity of ceftobiprole, linezolid, tigecycline, and 23 other antimicrobial agents against Staphylococcus aureus isolates in China[J]. Diagn Microbiol Infect Dis, 2008, 62(2): 226-229. DOI:10.1016/j.diagmicrobio.2008.06.003 |
| [10] | Holden MT, Hsu LY, Kurt K, et al. A genomic portrait of the emergence, evolution, and global spread of a methicillin-resistant Staphylococcus aureus pandemic[J]. Genome Res, 2013, 23(4): 653-664. DOI:10.1101/gr.147710.112 |
| [11] | Kim MN, Hwang SH, Pyo YJ, et al. Clonal spread of Staphylococcus aureus heterogeneously resistant to vancomycin in a university hospital in Korea[J]. J Clin Microbiol, 2002, 40(4): 1376-1380. DOI:10.1128/JCM.40.4.1376-1380.2002 |
| [12] | Cha HY, Moon DC, Choi CH, et al. Prevalence of the ST239 clone of methicillin-resistant Staphylococcus aureus and differences in antimicrobial susceptibilities of ST239 and ST5 clones identified in a Korean hospital[J]. J Clin Microbiol, 2005, 43(8): 3610-3614. DOI:10.1128/JCM.43.8.3610-3614.2005 |
| [13] | Ma XX, Ito T, Chongtrakool P, et al. Predominance of clones carrying Panton-Valentine leukocidin genes among methicillin-resistant Staphylococcus aureus strains isolated in Japanese hospitals from 1979 to 1985[J]. J Clin Microbiol, 2006, 44(12): 4515-4527. DOI:10.1128/JCM.00985-06 |
| [14] | Ip M, Yung RW, Ng TK, et al. Contemporary methicillin-resistant Staphylococcus aureus clones in Hong Kong[J]. J Clin Microbiol, 2005, 43(10): 5069-5073. DOI:10.1128/JCM.43.10.5069-5073.2005 |
| [15] | Cha HY, Moon DC, Choi CH, et al. Prevalence of the ST239 clone of methicillin-resistant Staphylococcus aureus and differences in antimicrobial susceptibilities of ST239 and ST5 clones identified in a Korean hospital[J]. J Clin Microbiol, 2005, 43(8): 3610-3614. DOI:10.1128/JCM.43.8.3610-3614.2005 |
| [16] | Botelho AM, Costa MO, Beltrame CO, et al. Complete Genome Sequence of the MRSA Isolate HC1335 from ST239 Lineage Displaying a Truncated AgrC Histidine Kinase Receptor[J]. Genome Biol Evol, 2016, 8(10): 3187-3192. DOI:10.1093/gbe/evw225 |
| [17] | Liu Y, Wang H, Du N, et al. Molecular evidence for spread of two major methicillin-resistant Staphylococcus aureus clones with a unique geographic distribution in Chinese hospitals[J]. Antimicrob Agents Chemother, 2009, 53(2): 512-518. DOI:10.1128/AAC.00804-08 |
| [18] | 刘颖超, 耿文静, 吴德静, 等. 中国七城市儿童耐甲氧西林金黄色葡萄球菌感染分离株分子学特征的研究[J]. 中华儿科杂志, 2012, 50(1): 38-44. |
| [19] | Wang L, Liu Y, Yang Y, et al. Multidrug-resistant clones of community-associated meticillin-resistant Staphylococcus aureus isolated from Chinese children and the resistance genes to clindamycin and mupirocin[J]. J Med Microbiol, 2012, 61(Pt 9): 1240-1247. DOI:10.1099/jmm.0.042663-0 |
| [20] | Mcdougal LK, Steward CD, Killgore GE, et al. Pulsed-field gel electrophoresis typing of oxacillin-resistant Staphylococcus aureus isolates from the United States: establishing a national database[J]. J Clin Microbiol, 2003, 41(11): 5113-5120. DOI:10.1128/JCM.41.11.5113-5120.2003 |
| [21] | Stemper ME, Brady JM, Qutaishat SS, et al. Shift in Staphylococcus aureus clone linked to an infected tattoo[J]. Emerg Infect Dis, 2006, 12(9): 1444-1446. DOI:10.3201/eid1209.051634 |
| [22] | Cai Y, Kong F, Wang Q, et al. Comparison of single-and multilocus sequence typing and toxin gene profiling for characterization of methicillin-resistant Staphylococcus aureus[J]. J Clin Microbiol, 2007, 45(10): 3302-3308. DOI:10.1128/JCM.01082-07 |
| [23] | Adcock PM, Pastor P, Medley F, et al. Methicillin-resistant Staphylococcus aureus in two child care centers[J]. J Infect Dis, 1998, 178(2): 577-580. DOI:10.1086/517478 |
| [24] | Diep BA, Chambers HF, Graber CJ, et al. Emergence of multidrug-resistant, community-associated, methicillin-resistant Staphylococcus aureus clone USA300 in men who have sex with men[J]. Ann Intern Med, 2008, 148(4): 249-257. DOI:10.7326/0003-4819-148-4-200802190-00204 |
| [25] | Miller LG, Diep BA. Clinical practice: colonization, fomites, and virulence: rethinking the pathogenesis of community-associated methicillin-resistant Staphylococcus aureus infection[J]. Clin Infect Dis, 2008, 46(5): 752-760. DOI:10.1086/526773 |
| [26] | Kennedy AD, Otto M, Braughton KR, et al. Epidemic community-associated methicillin-resistant Staphylococcus aureus: recent clonal expansion and diversification[J]. Proc Natl Acad Sci U S A, 2008, 105(4): 1327-1332. DOI:10.1073/pnas.0710217105 |
| [27] | Botelho AM, Costa MO, Beltrame CO, et al. Complete Genome Sequence of the MRSA Isolate HC1335 from ST239 Lineage Displaying a Truncated AgrC Histidine Kinase Receptor[J]. Genome Biol Evol, 2016, 8(10): 3187-3192. DOI:10.1093/gbe/evw225 |
| [28] | Tristan A, Bes M, Meugnier H, et al. Global distribution of Panton-Valentine leukocidin--positive methicillin-resistant Staphylococcus aureus, 2006[J]. Emerg Infect Dis, 2007, 13(4): 594-600. DOI:10.3201/eid1304.061316 |
| [29] | Liu Y, Geng W, Yang Y, et al. Susceptibility to and resistance determinants of fusidic acid in Staphylococcus aureus isolated from Chinese children with skin and soft tissue infections[J]. FEMS Immunol Med Microbiol, 2012, 64(2): 212-218. DOI:10.1111/j.1574-695X.2011.00887.x |
| [30] | Wu D, Li X, Yang Y, et al. Superantigen gene profiles and presence of exfoliative toxin genes in community-acquired meticillin-resistant Staphylococcus aureus isolated from Chinese children[J]. J Med Microbiol, 2011, 60(Pt 1): 35-45. DOI:10.1099/jmm.0.023465-0 |
| [31] | Munzenmayer L, Geiger T, Daiber E, et al. Influence of Sae-regulated and Agr-regulated factors on the escape of Staphylococcus aureus from human macrophages[J]. Cell Microbiol, 2016, 18(8): 1172-1183. DOI:10.1111/cmi.12577 |
| [32] | Li J, Wang L, Ip M, et al. Molecular and clinical characteristics of clonal complex 59 methicillin-resistant Staphylococcus aureus infections in Mainland China[J]. PLoS One, 2013, 8(8): e70602. DOI:10.1371/journal.pone.0070602 |
| [33] | Matic G, Bosch T, Ramlow W. Background and indications for protein A-based extracorporeal immunoadsorption[J]. Ther Apher, 2001, 5(5): 394-403. DOI:10.1046/j.1526-0968.2001.00370.x |
| [34] | Kaneko J, Kamio Y. Bacterial two-component and hetero-heptameric pore-forming cytolytic toxins: structures, pore-forming mechanism, and organization of the genes[J]. Biosci Biotechnol Biochem, 2004, 68(5): 981-1003. DOI:10.1271/bbb.68.981 |
| [35] | Berube BJ, Sampedro GR, Otto M, et al. The psmalpha locus regulates production of Staphylococcus aureus alpha-toxin during infection[J]. Infect Immun, 2014, 82(8): 3350-3358. DOI:10.1128/IAI.00089-14 |
| [36] | Wang R, Braughton K R, Kretschmer D, et al. Identification of novel cytolytic peptides as key virulence determinants for community-associated MRSA[J]. Nat Med, 2007, 13(12): 1510-1514. DOI:10.1038/nm1656 |
| [37] | Bunter JP, Seth-Smith HM, Ruegg S, et al. Wild type agr-negative livestock-associated MRSA exhibits high adhesive capacity to human and porcine cells[J]. Res Microbiol, 2016. DOI:10.1016/j.resmic.2016.09.006 |
| [38] | Cheung GY, Wang R, Khan BA, et al. Role of the accessory gene regulator agr in community-associated methicillin-resistant Staphylococcus aureus pathogenesis[J]. Infect Immun, 2011, 79(5): 1927-1935. DOI:10.1128/IAI.00046-11 |
| [39] | Li M, Dai Y, Zhu Y, et al. Virulence determinants associated with the Asian community-associated methicillin-resistant Staphylococcus aureus lineage ST59[J]. Sci Rep, 2016, 6: 27899. DOI:10.1038/srep27899 |
| [40] | Li S, Sun J, Zhang J, et al. Comparative analysis of the virulence characteristics of epidemic methicillin-resistant Staphylococcus aureus (MRSA) strains isolated from Chinese children: ST59 MRSA highly expresses core gene-encoded toxin[J]. APMIS, 2014, 122(2): 101-114. DOI:10.1111/apm.12105 |
| [41] | Cheung GY, Duong AC, Otto M. Direct and synergistic hemolysis caused by Staphylococcus phenol-soluble modulins: implications for diagnosis and pathogenesis[J]. Microbes Infect, 2012, 14(4): 380-386. DOI:10.1016/j.micinf.2011.11.013 |
| [42] | Berube BJ, Bubeck WJ. Staphylococcus aureus alpha-toxin: nearly a century of intrigue[J]. Toxins (Basel), 2013, 5(6): 1140-1166. DOI:10.3390/toxins5061140 |
| [43] | Qin L, Mccausland JW, Cheung GY, et al. PSM-Mec-A Virulence Determinant that Connects Transcriptional Regulation, Virulence, and Antibiotic Resistance in Staphylococci[J]. Front Microbiol, 2016, 7: 1293. DOI:10.3389/fmicb.2016.01293 |
| [44] | Liu Q, Yeo W S, Bae T. The SaeRS Two-Component System of Staphylococcus aureus[J]. Genes (Basel), 2016, 7(10). DOI:10.3390/genes7100081 |
| [45] | Queck SY, Jameson-Lee M, Villaruz AE, et al. RNAⅢ-independent target gene control by the agr quorum-sensing system: insight into the evolution of virulence regulation in Staphylococcus aureus[J]. Mol Cell, 2008, 32(1): 150-158. DOI:10.1016/j.molcel.2008.08.005 |
| [46] | Coleman D, Knights J, Russell R, et al. Insertional inactivation of the Staphylococcus aureus beta-toxin by bacteriophage phi 13 occurs by site-and orientation-specific integration of the phi 13 genome[J]. Mol Microbiol, 1991, 5(4): 933-939. DOI:10.1111/mmi.1991.5.issue-4 |
| [47] | Jarraud S, Lyon GJ, Figueiredo AM, et al. Exfoliatin-producing strains define a fourth agr specificity group in Staphylococcus aureus[J]. J Bacteriol, 2000, 182(22): 6517-6522. DOI:10.1128/JB.182.22.6517-6522.2000 |
| [48] | Traber K, Novick R. A slipped-mispairing mutation in AgrA of laboratory strains and clinical isolates results in delayed activation of agr and failure to translate delta-and alpha-haemolysins[J]. Mol Microbiol, 2006, 59(5): 1519-1530. DOI:10.1111/j.1365-2958.2006.04986.x |
| [49] | Shopsin B, Drlica-Wagner A, Mathema B, et al. Prevalence of agr dysfunction among colonizing Staphylococcus aureus strains[J]. J Infect Dis, 2008, 198(8): 1171-1174. DOI:10.1086/592051 |
| [50] | Mcnamara PJ, Milligan-Monroe KC, Khalili S, et al. Identification, cloning, and initial characterization of rot, a locus encoding a regulator of virulence factor expression in Staphylococcus aureus[J]. J Bacteriol, 2000, 182(11): 3197-3203. DOI:10.1128/JB.182.11.3197-3203.2000 |
| [51] | Li D, Cheung A. Repression of hla by rot is dependent on sae in Staphylococcus aureus[J]. Infect Immun, 2008, 76(3): 1068-1075. DOI:10.1128/IAI.01069-07 |
 2017, Vol. 26
2017, Vol. 26




